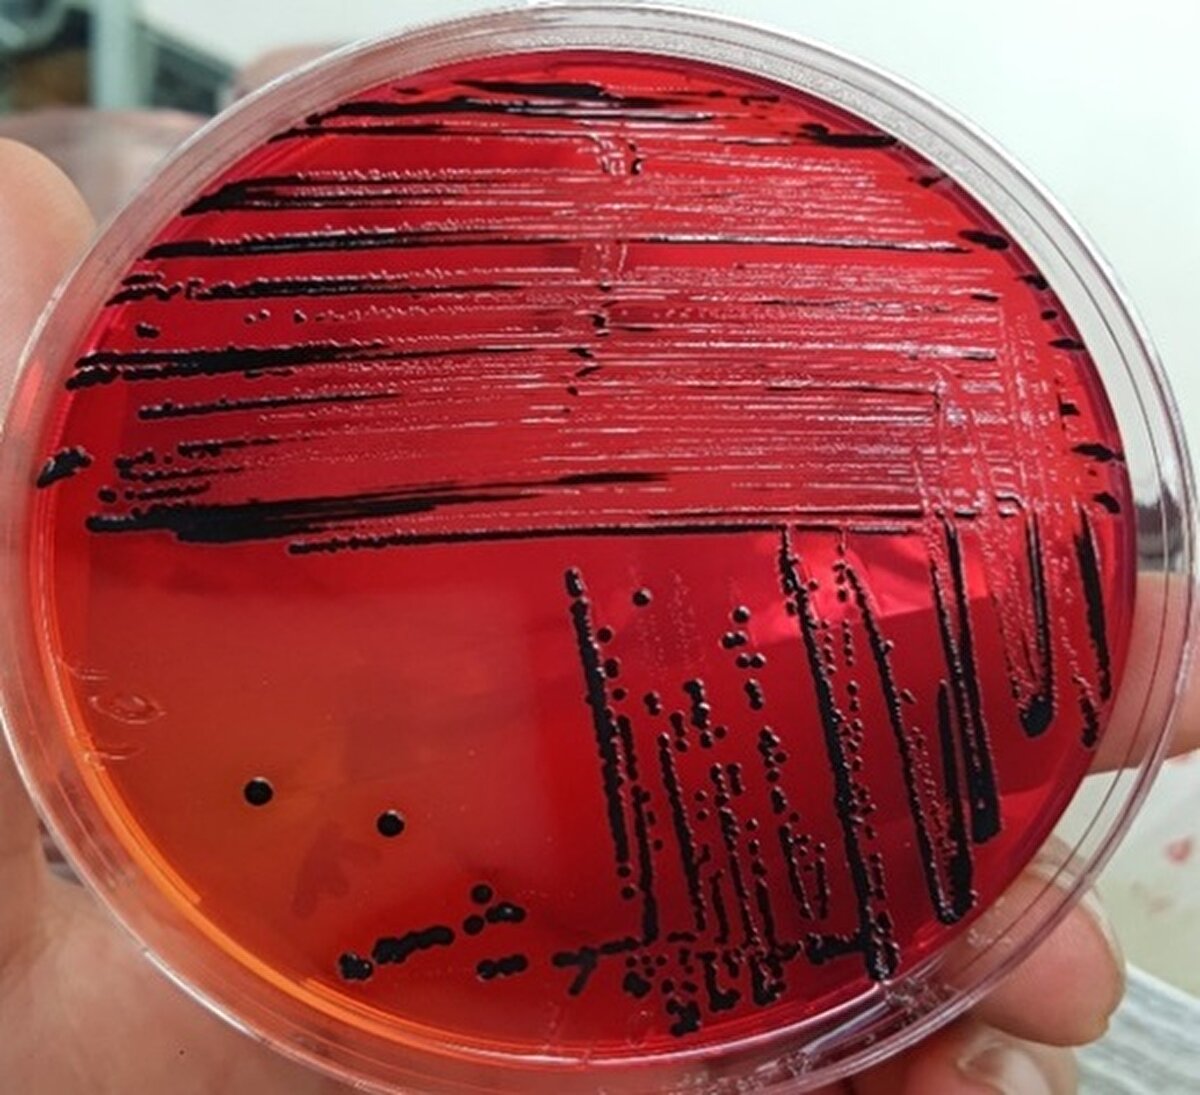
Çalışmada ürünlerin mikrobiyolojik açıdan kirli olduğu ortaya kondu.

Çiğ köftede 'salmonella' ve 'bağırsak kökenli bakteri' tehlikesi

Çukurova Üniversitesi (ÇÜ) Mühendislik Fakültesi Gıda Mühendisliği Bölümü Öğretim Üyesi Prof. Dr. Işıl Var, çiğ köftenin mikrobiyolojik açıdan insan sağlığına etkisini incelediği çalışmasında, salmonella ve kötü hijyen koşullarından kaynaklanan bağırsak kökenli bakteriler saptadıklarını açıkladı.
1-12
Bulgur, isot, kıyılmış et, salça, soğan, maydanoz ve çeşitli baharatların yoğurulup karıştırılması ile hazırlanan, pişirilmeden tüketilen yöresel bir ürün olan çiğ köfte, pek çok restoranda ikram edilirken, zincir bayilerin yanı sıra marketlerde de özel olarak açılan reyonlarda satışa sunuluyor.
2-12
Avrupa Birliği standartlarına uyum amacıyla 2008'de yapılan bir düzenlemeyle içinde et kullanımı yasaklanan çiğ köfte, özellikle Doğu ve Güneydoğu Anadolu bölgelerinde evlerde de genellikle etli olarak yapılıp tüketiliyor.
3-12
ÇİĞ KÖFTE LABORATUVAR ORTAMINDA İNCELENDİ
ÇÜ Mühendislik Fakültesi Gıda Mühendisliği Bölümü Öğretim Üyesi Prof. Dr. Işıl Var, öğrencileri ile birlikte laboratuvar ortamında Türkiye'de severek tüketilen çiğ köftenin mikrobiyolojik açıdan insan sağlığı üzerindeki etkisini inceledi. Çalışma kapsamında marketlerden, zincir bayilerden ve restoranlardan alınan çiğ köftelerin yanı sıra öğrenciler, evlerde aile bireylerinin yaptığı örnekleri de laboratuvara getirdi.
4-12
Ayrıca Prof. Dr. Işıl Var ile öğrenciler laboratuvar koşullarında tüm malzemeleri steril hale getirerek çiğ köfte yaptı.
5-12
Tüm bu örnekler incelendiğinde, etli olan çiğ köftelerin tamamına yakınında Salmonella bakterisine rastlanırken, etli ve etsiz diğer örneklerde ise kötü hijyen koşullarından kaynaklanan 'E.coli' ve 'E.coli O157:H7' adı verilen bağırsak kökenli bakteriler görüldü.
7-12
SALMONELLA VE BAĞIRSAK KÖKENLİ BAKTERİ ÇIKTI
Araştırmayla ilgili bilgi veren Prof. Dr. Işıl Var, şöyle konuştu:
8-12
"Gıda incelemeleri uzun yıllar alan çalışmalar gerektiriyor. 2000'li yıllarda başladığım bu çalışma hala ara ara devam ediyor. Bu kapsamda dışarıdan aldığımız örneklerin yanı sıra öğrencilerimle laboratuvar ortamında da çiğ köfte yaptık. Hatta öğrenciler aile bireylerinin yaptığı çiğ köfteleri de getirdiler.
9-12
Yaklaşık 250 örneği inceledik. Etli olan örneklerin tamamına yakınında salmonella bakterisi ile karşılaştık. Etsiz çalıştığımız çiğ köfte örneklerinin bazılarında da yine salmonella ile karşılaştık ama salmonella dışındaki diğer bağırsak kökenli bakterilerin de çok fazla olduğunu tespit ettik. Bu bakterilerin içinde; bağırsak iltihaplanmasına neden olabilen bir 'E. coli' olduğu gibi, kolera benzeri bir ishalle, su kaybına neden olup gelişmekte olan ülkelerde yetersiz beslenme koşullarında çocuk ölümlerine sebebiyet verebilen koli basilleri de saptadık."
10-12
'MÜMKÜNSE ETSİZ TÜKETİN'
El ile hazırlanan ve ısıl işlem görmeyip pişirilmeden sofralara getirilen geleneksel birçok gıda ürününün sağlık açısından risk taşıdığı konusunda uyarılarda bulunan Prof. Dr. Işıl Var, "Çiğ köftelerde görülen bu sorunun temel nedeni bu ürünlerin hijyenik olmayan koşullarda el ile hazırlanması ve sonrasında da ısıl işlem görmemesidir.
11-12